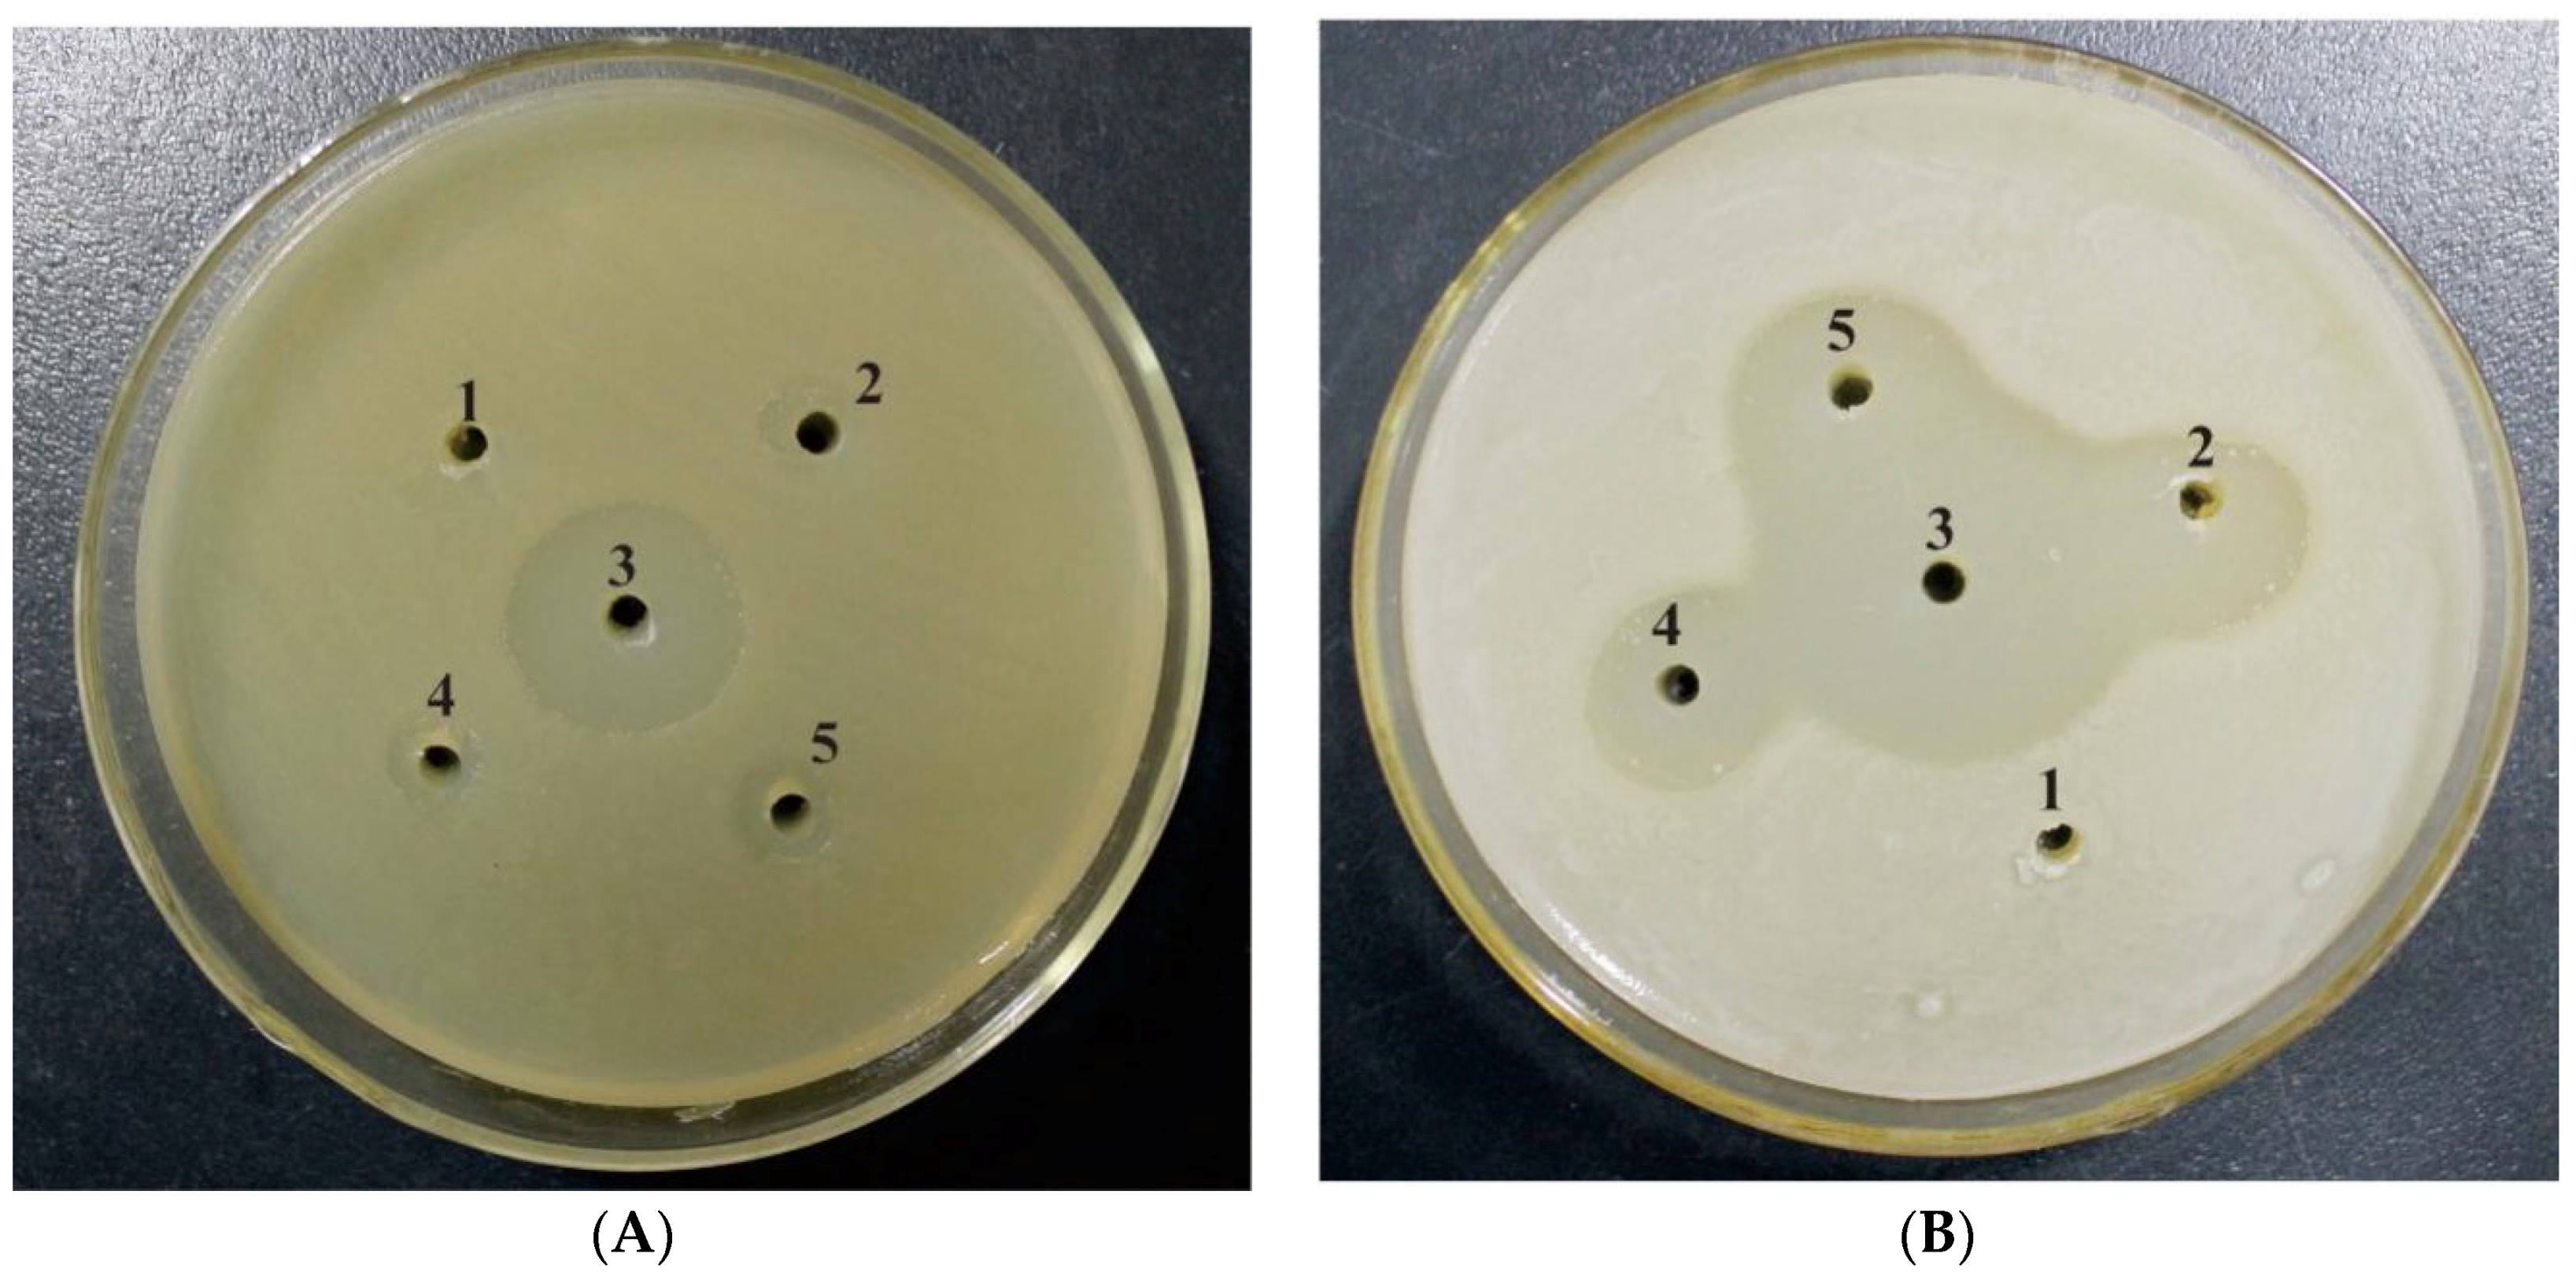

Expression, Purification and Antibacterial Activity of NK-Lysin Mature Peptides from the Channel Catfish (Ictalurus punctatus)
Abstract
:1. Introduction
2. Materials and Methods
2.1. Extraction of RNA, Reverse-Transcription (RT)-PCR and Sequence Analysis
2.2. Expression and Purification of mNKLs
2.3. Enterokinase Cleavage of mNKLs
2.4. Antibacterial Activity Assays
3. Results
3.1. Cloning and Construction of Recombinant Expression Vector
3.2. Expression and Affinity Column Purification of Fusion mNKLs
3.3. Cleavage and Purification of mNKLs
3.4. Antibacterial Activity of the Peptide mNKLs
4. Discussion
5. Conclusions
Acknowledgments
Author Contributions
Conflicts of Interest
References
- Ernst, W.A.; Thoma-Uszynski, S.; Teitelbaum, R.; Ko, C.; Hanson, D.A.; Clayberger, C.; Krensky, A.M.; Leippe, M.; Bloom, B.R.; Ganz, T.; et al. Granulysin, a T cell product, kills bacteria by altering membrane permeability. J. Immunol. 2000, 165, 7102–7108. [Google Scholar] [CrossRef] [PubMed]
- Gansert, J.L.; Kieβler, V.; Engele, M.; Wittke, F.; Röllinghoff, M.; Krensky, A.M.; Porcelli, S.A.; Modlin, R.L.; Stenger, S. Human NKT cells express granulysin and exhibit antimycobacterial activity. J. Immunol. 2003, 170, 3154–3161. [Google Scholar] [CrossRef] [PubMed]
- Mcphee, J.B.; Hancock, R.E. Function and therapeutic potential of host defence peptides. J. Pept. Sci. 2005, 11, 677–687. [Google Scholar] [CrossRef] [PubMed]
- Stenger, S.; Hanson, D.A.; Teitelbaum, R.; Dewan, P.; Niazi, K.R.; Froelich, C.J.; Ganz, T.; Thoma-Uszynski, S.; Melián, A.N.; Bogdan, C. An antimicrobial activity of cytolytic T cells mediated by granulysin. Science 1998, 282, 121–125. [Google Scholar] [CrossRef] [PubMed]
- Zanetti, M.; Gennaro, R.; Skerlavaj, B.; Tomasinsig, L.; Circo, R. Cathelicidin peptides as candidates for a novel class of antimicrobials. Curr. Pharm. Des. 2002, 8, 779–793. [Google Scholar] [CrossRef] [PubMed]
- Zasloff, M. Inducing endogenous antimicrobial peptides to battle infections. Proc. Natl. Acad. Sci. USA 2006, 103, 8913–8914. [Google Scholar] [CrossRef] [PubMed]
- Boman, H.G.; Nilsson, I.; Rasmuson, B. Inducible antibacterial defence system in drosophila. Nature 1972, 237, 232–235. [Google Scholar] [CrossRef] [PubMed]
- Guaní-Guerra, E.; Santos-Mendoza, T.; Lugo-Reyes, S.O.; Terán, L.M. Antimicrobial peptides: General overview and clinical implications in human health and disease. Clin. Immunol. 2010, 135, 1–11. [Google Scholar] [CrossRef] [PubMed]
- Hwang, J.-S.; Lee, J.; Kim, Y.-J.; Bang, H.-S.; Yun, E.-Y.; Kim, S.-R.; Suh, H.-J.; Kang, B.-R.; Nam, S.-H.; Jeon, J.-P. Isolation and characterization of a defensin-like peptide (Coprisin) from the dung beetle, Copris tripartitus. Int. J. Pept. 2009. [Google Scholar] [CrossRef] [PubMed]
- Lee, J.-Y.; Boman, A.; Sun, C.; Andersson, M.; Jörnvall, H.; Mutt, V.; Boman, H.G. Antibacterial peptides from pig intestine: Isolation of a mammalian cecropin. Proc. Natl. Acad. Sci. USA 1989, 86, 9159–9162. [Google Scholar] [CrossRef] [PubMed]
- Rollins-Smith, L.A. The role of amphibian antimicrobial peptides in protection of amphibians from pathogens linked to global amphibian declines. BBA Biomembr. 2009, 1788, 1593–1599. [Google Scholar] [CrossRef] [PubMed]
- Pukala, T.L.; Bowie, J.H.; Maselli, V.M.; Musgrave, I.F.; Tyler, M.J. Host-defence peptides from the glandular secretions of amphibians: Structure and activity. Nat. Prod. Rep. 2006, 23, 368–393. [Google Scholar] [CrossRef] [PubMed]
- Berrocal-Lobo, M.; Molina, A.; Rodríguez-Palenzuela, P.; García-Olmedo, F.; Rivas, L. Leishmania donovani: Thionins, plant antimicrobial peptides with leishmanicidal activity. Exp. Parasitol. 2009, 122, 247–249. [Google Scholar] [CrossRef] [PubMed]
- Valero, Y.; Chaves-Pozo, E.; Meseguer, J.; Esteban, M.A.; Cuesta, A. Biological role of fish antimicrobial peptides. In Antimicrobial Peptides: Properties, Functions and Role in Immune Response; Nova Science Publisher: New York, NY, USA, 2013; pp. 31–60. [Google Scholar]
- Cole, A.M.; Weis, P.; Diamond, G. Isolation and characterization of pleurocidin, an antimicrobial peptide in the skin secretions of winter flounder. J. Biol. Chem. 1997, 272, 12008–12013. [Google Scholar] [CrossRef] [PubMed]
- Lauth, X.; Shike, H.; Burns, J.C.; Westerman, M.E.; Ostland, V.E.; Carlberg, J.M.; Van Olst, J.C.; Nizet, V.; Taylor, S.W.; Shimizu, C. Discovery and characterization of two isoforms of moronecidin, a novel antimicrobial peptide from hybrid striped bass. J. Biol. Chem. 2002, 277, 5030–5039. [Google Scholar] [CrossRef] [PubMed]
- Rajanbabu, V.; Chen, J.-Y. Applications of antimicrobial peptides from fish and perspectives for the future. Peptides 2011, 32, 415–420. [Google Scholar] [CrossRef] [PubMed]
- Zhang, Y.-A.; Zou, J.; Chang, C.-I.; Secombes, C.J. Discovery and characterization of two types of liver-expressed antimicrobial peptide 2 (LEAP-2) genes in rainbow trout. Vet. Immunol. Immunopathol. 2004, 101, 259–269. [Google Scholar] [CrossRef] [PubMed]
- Zanetti, M. Cathelicidins, multifunctional peptides of the innate immunity. J. Leukoc. Biol. 2004, 75, 39–48. [Google Scholar] [CrossRef] [PubMed]
- Oppenheim, J.; Biragyn, A.; Kwak, L.; Yang, D. Roles of antimicrobial peptides such as defensins in innate and adaptive immunity. Ann. Rheum. Dis. 2003, 62, ii17–ii21. [Google Scholar] [CrossRef] [PubMed]
- Bruhn, H.; Riekens, B.; Berninghausen, O.; Leippe, M. Amoebapores and NK-lysin, members of a class of structurally distinct antimicrobial and cytolytic peptides from protozoa and mammals: A comparative functional analysis. Biochem. J. 2003, 375, 737–744. [Google Scholar] [CrossRef] [PubMed]
- Wang, Q.; Wang, Y.; Xu, P.; Liu, Z. NK-lysin of channel catfish: Gene triplication, sequence variation, and expression analysis. Mol. Immunol. 2006, 43, 1676–1686. [Google Scholar] [CrossRef] [PubMed]
- Concha, M.I.; Smith, V.J.; Castro, K.; Bastias, A.; Romero, A.; Amthauer, R.J. Apolipoproteins A-I and A-II are potentially important effectors of innate immunity in the teleost fish Cyprinus carpio. Eur. J. Biochem. 2004, 271, 2984–2990. [Google Scholar] [CrossRef] [PubMed]
- Subramanian, S.; Ross, N.W.; MacKinnon, S.L. Myxinidin, a novel antimicrobial peptide from the epidermal mucus of hagfish, Myxine glutinosa L. Mar. Biotechnol. 2009, 11, 748–757. [Google Scholar] [CrossRef] [PubMed]
- Park, C.B.; Lee, J.H.; Park, I.Y.; Kim, M.S.; Kim, S.C. A novel antimicrobial peptide from the loach, Misgurnus anguillicaudatus. FEBS Lett. 1997, 411, 173–178. [Google Scholar] [CrossRef]
- Andersson, M.; Gunne, H.; Agerberth, B.; Boman, A.; Bergman, T.; Olsson, B.; Dagerlind, Å.; Wigzell, H.; Boman, H.; Gudmundsson, G. NK-lysin, structure and function of a novel effector molecule of porcine T and NK cells. Vet. Immunol. Immunopathol. 1996, 54, 123–126. [Google Scholar] [CrossRef]
- Liepinsh, E.; Andersson, M.; Ruysschaert, J.-M.; Otting, G. Saposin fold revealed by the NMR structure of NK-lysin. Nat. Struct. Biol. 1997, 4, 793–795. [Google Scholar] [CrossRef] [PubMed]
- Andersson, M.; Gunne, H.; Agerberth, B.; Boman, A.; Bergman, T.; Sillard, R.; Jörnvall, H.; Mutt, V.; Olsson, B.; Wigzell, H. NK-lysin, a novel effector peptide of cytotoxic T and NK cells. Structure and CDNA cloning of the porcine form, induction by interleukin 2, antibacterial and antitumour activity. EMBO J. 1995, 14, 1615–1625. [Google Scholar] [PubMed]
- Hirono, I.; Kondo, H.; Koyama, T.; Arma, N.R.; Hwang, J.Y.; Nozaki, R.; Midorikawa, N.; Aoki, T. Characterization of Japanese flounder (Paralichthys olivaceus) NK-lysin, an antimicrobial peptide. Fish Shellfish Immunol. 2007, 22, 567–575. [Google Scholar] [CrossRef] [PubMed]
- Endsley, J.J.; Furrer, J.L.; Endsley, M.A.; McIntosh, M.A.; Maue, A.C.; Waters, W.R.; Lee, D.R.; Estes, D.M. Characterization of bovine homologues of granulysin and NK-lysin. J. Immunol. 2004, 173, 2607–2614. [Google Scholar] [CrossRef] [PubMed]
- Davis, E.G.; Sang, Y.; Rush, B.; Zhang, G.; Blecha, F. Molecular cloning and characterization of equine NK-lysin. Vet. Immunol. Immunopathol. 2005, 105, 163–169. [Google Scholar] [CrossRef] [PubMed]
- Lee, M.O.; Jang, H.-J.; Han, J.Y.; Womack, J.E. Chicken NK-lysin is an alpha-helical cationic peptide that exerts its antibacterial activity through damage of bacterial cell membranes. Poult. Sci. 2014, 93, 864–870. [Google Scholar] [CrossRef] [PubMed]
- Wang, Q.; Bao, B.; Wang, Y.; Peatman, E.; Liu, Z. Characterization of a NK-lysin antimicrobial peptide gene from channel catfish. Fish Shellfish Immunol. 2006, 20, 419–426. [Google Scholar] [CrossRef] [PubMed]
- Pereiro, P.; Varela, M.; Díaz-Rosales, P.; Romero, A.; Dios, S.; Figueras, A.; Novoa, B. Zebrafish NK-lysins: First insights about their cellular and functional diversification. Dev. Comp. Immunol. 2015, 51, 148–159. [Google Scholar] [CrossRef] [PubMed]
- Zhang, M.; Long, H.; Sun, L. A NK-lysin from Cynoglossus semilaevis enhances antimicrobial defense against bacterial and viral pathogens. Dev. Comp. Immunol. 2013, 40, 258–265. [Google Scholar] [CrossRef] [PubMed]
- Feng, X.-J.; Wang, J.-H.; Shan, A.-S.; Teng, D.; Yang, Y.-L.; Yao, Y.; Yang, G.-P.; Shao, Y.-C.; Liu, S.; Zhang, F. Fusion expression of bovine lactoferricin in Escherichia coli. Protein Expr. Purif. 2006, 47, 110–117. [Google Scholar] [CrossRef] [PubMed]
- Kocabas, A.M.; Li, P.; Cao, D.; Karsi, A.; He, C.; Patterson, A.; Ju, Z.; Dunham, R.A.; Liu, Z. Expression profile of the channel catfish spleen: Analysis of genes involved in immune functions. Mar. Biotechnol. 2002, 4, 526–536. [Google Scholar] [CrossRef] [PubMed]
- Pridgeon, J.W.; Mu, X.; Klesius, P.H. Expression profiles of seven channel catfish antimicrobial peptides in response to Edwardsiella ictaluri infection. J. Fish Dis. 2012, 35, 227–237. [Google Scholar] [CrossRef]
- Demain, A.L.; Vaishnav, P. Production of recombinant proteins by microbes and higher organisms. Biotechnol. Adv. 2009, 27, 297–306. [Google Scholar] [CrossRef] [PubMed]
- Terpe, K. Overview of bacterial expression systems for heterologous protein production: From molecular and biochemical fundamentals to commercial systems. Appl. Microbiol. Biotechnol. 2006, 72, 211–222. [Google Scholar] [CrossRef] [PubMed]
- Fischer, B.; Sumner, I.; Goodenough, P. Isolation, renaturation, and formation of disulfide bonds of eukaryotic proteins expressed in Escherichia coli as inclusion bodies. Biotechnol. Bioeng. 1993, 41, 3–13. [Google Scholar] [CrossRef] [PubMed]
- Tao, Y.; Zhao, D.-M.; Wen, Y. Expression, purification and antibacterial activity of the channel catfish hepcidin mature peptide. Protein Expr. Purif. 2014, 94, 73–78. [Google Scholar] [CrossRef] [PubMed]
- Li, Y. Carrier proteins for fusion expression of antimicrobial peptides in Escherichia coli. Biotechnol. Appl. Biochem. 2009, 54, 1–9. [Google Scholar] [CrossRef] [PubMed]
- Weidner, M.; Taupp, M.; Hallam, S.J. Expression of recombinant proteins in the methylotrophic yeast Pichia pastoris. J. Vis. Exp. 2010, 25. [Google Scholar] [CrossRef] [PubMed]
- Jin, F.; Xu, X.; Wang, L.; Zhang, W.; Gu, D. Expression of recombinant hybrid peptide cecropinA(1–8)–magainin2(1–12) in Pichia pastoris: Purification and characterization. Protein Expr. Purif. 2006, 50, 147–156. [Google Scholar] [CrossRef] [PubMed]
- Neidhardt, F.C.; Curtiss, R. Escherichia coli and Salmonella: Cellular and Molecular Biology; ASM Press: Washington, DC, USA, 1996. [Google Scholar]
- Xu, Z.; Zhong, Z.; Huang, L.; Peng, L.; Wang, F.; Cen, P. High-level production of bioactive human beta-defensin-4 in Escherichia coli by soluble fusion expression. Appl. Microbiol. Biotechnol. 2006, 72, 471–479. [Google Scholar] [CrossRef]
- Shen, Y.; Ai, H.-X.; Song, R.; Liang, Z.-N.; Li, J.-F.; Zhang, S.-Q. Expression and purification of moricin CM4 and human β-defensins 4 in Escherichia coli using a new technology. Microbiol. Res. 2010, 165, 713–718. [Google Scholar] [CrossRef] [PubMed]
- Zhai, Q.; Ye, J.; Mo, J.; Zhang, H.-Z. Fusion expression of cecropin P1 in Escherichia coli and its antimicrobial activity analysis. Food Drug 2011, 1, 1–4. [Google Scholar]
- Skosyrev, V.S.; Kulesskiy, E.A.; Yakhnin, A.V.; Temirov, Y.V.; Vinokurov, L.M. Expression of the recombinant antibacterial peptide sarcotoxin IA in Escherichia coli cells. Protein Expr. Purif. 2003, 28, 350–356. [Google Scholar] [CrossRef]
- Cao, W.; Zhou, Y.; Ma, Y.; Luo, Q.; Wei, D. Expression and purification of antimicrobial peptide adenoregulin with C-amidated terminus in escherichia coli. Protein Expr. Purif. 2005, 40, 404–410. [Google Scholar] [CrossRef] [PubMed]
- Wen, Y.; Tao, Y. Hepcidin from tilapia, oreochromis niloticus: Its fusion expression in Escherichia coli and antimicrobial activity. J. Shanghai Jiaotong Univ. (Agric. Sci.) 2012, 30, 68–75. [Google Scholar]
- Moon, W.J.; Hwang, D.K.; Park, E.J.; Kim, Y.M.; Chae, Y.K. Recombinant expression, isotope labeling, refolding, and purification of an antimicrobial peptide, piscidin. Protein Expr. Purif. 2007, 51, 141–146. [Google Scholar] [CrossRef] [PubMed]
- Liu, F.; Li, J.-L.; Yue, G.-H.; Fu, J.-J.; Zhou, Z.-F. Molecular cloning and expression analysis of the liver-expressed antimicrobial peptide 2 (LEAP-2) gene in grass carp. Vet. Immunol. Immunopathol. 2010, 133, 133–143. [Google Scholar] [CrossRef] [PubMed]
- Lavallie, E.R.; Diblasio, E.A.; Kovacic, S.; Grant, K.L.; Schendel, P.F.; Mccoy, J.M. A thioredoxin gene fusion expression system that circumvents inclusion body formation in the E. coli cytoplasm. Biotechnology 1993, 11, 187–193. [Google Scholar] [CrossRef] [PubMed]
- Jacobs, T.; Bruhn, H.; Gaworski, I.; Fleischer, B.; Leippe, M. NK-lysin and its shortened analog NK-2 exhibit potent activities against Trypanosoma cruzi. Antimicrob. Agents Chemother. 2003, 47, 607–613. [Google Scholar] [CrossRef] [PubMed]
- Hancock, R.E.; Rozek, A. Role of membranes in the activities of antimicrobial cationic peptides. FEMS Microbiol. Lett. 2002, 206, 143–149. [Google Scholar] [CrossRef] [PubMed]

| Primer Name | Sequences (5′ to 3′) | GenBank ID |
|---|---|---|
| mNKL1 forward primer | CGGGATCCGACGACGACGACAAGCCTGGTGCCTGTTG | AY934592 |
| mNKL1 reverse primer | CCAAGCTTTCAGCAAATACCAAGATTAC | |
| mNKL2 forward primer | CGGGATCCGACGACGACGACAAGCCTGGTGCCTGTTG | DQ153189 |
| mNKL2 reverse primer | CCAAGCTTCTAGCAAATACCAATATTAACAC | |
| mNKL3 forward primer | CGGGATCCGACGACGACGACAAGCCTGGTCTGTGTTGGAT | DQ153187 |
| mNKL3 reverse primer | CCAAGCTTCTAGCAAATACCAATATTAACAC |
© 2016 by the authors; licensee MDPI, Basel, Switzerland. This article is an open access article distributed under the terms and conditions of the Creative Commons Attribution (CC-BY) license (http://creativecommons.org/licenses/by/4.0/).
Share and Cite
Cai, S.; Wang, J.; Wang, K.; Chen, D.; Dong, X.; Liu, T.; Zeng, Y.; Wang, X.; Wu, D. Expression, Purification and Antibacterial Activity of NK-Lysin Mature Peptides from the Channel Catfish (Ictalurus punctatus). Appl. Sci. 2016, 6, 240. https://doi.org/10.3390/app6090240
Cai S, Wang J, Wang K, Chen D, Dong X, Liu T, Zeng Y, Wang X, Wu D. Expression, Purification and Antibacterial Activity of NK-Lysin Mature Peptides from the Channel Catfish (Ictalurus punctatus). Applied Sciences. 2016; 6(9):240. https://doi.org/10.3390/app6090240
Chicago/Turabian StyleCai, Shurui, Jun Wang, Kaiyu Wang, Defang Chen, Xiaowei Dong, Tao Liu, Yukun Zeng, Xingli Wang, and Dongmei Wu. 2016. "Expression, Purification and Antibacterial Activity of NK-Lysin Mature Peptides from the Channel Catfish (Ictalurus punctatus)" Applied Sciences 6, no. 9: 240. https://doi.org/10.3390/app6090240
APA StyleCai, S., Wang, J., Wang, K., Chen, D., Dong, X., Liu, T., Zeng, Y., Wang, X., & Wu, D. (2016). Expression, Purification and Antibacterial Activity of NK-Lysin Mature Peptides from the Channel Catfish (Ictalurus punctatus). Applied Sciences, 6(9), 240. https://doi.org/10.3390/app6090240
